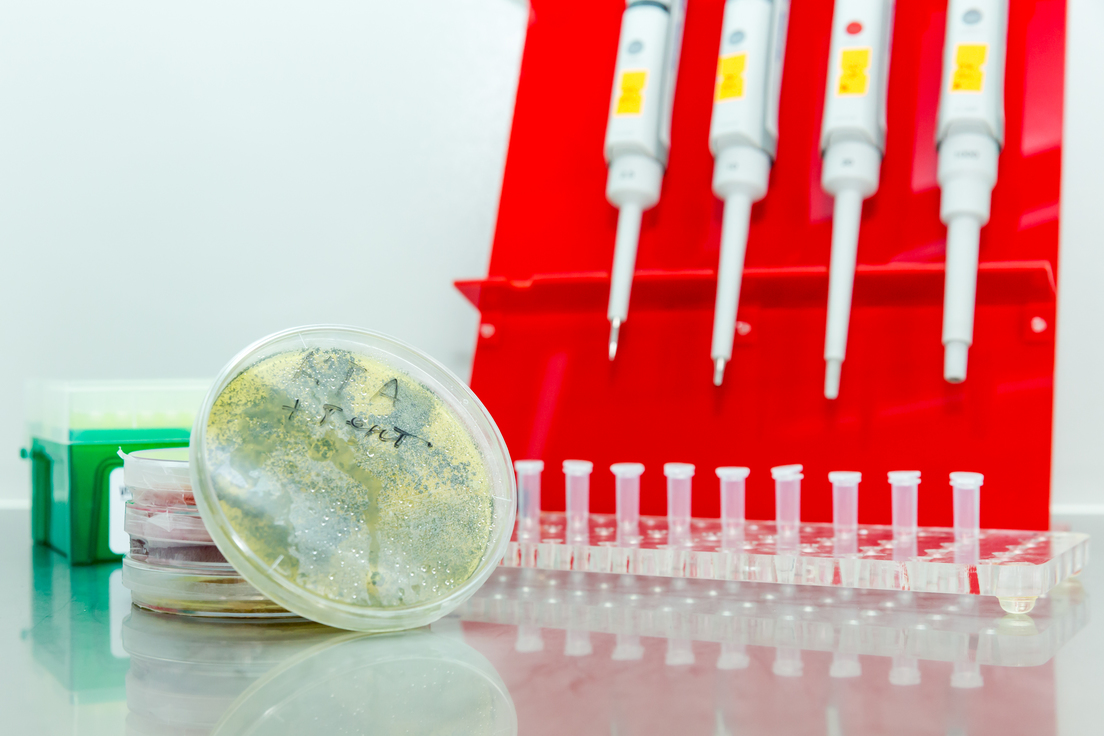

Varias universidades de Rusia trabajan en el desarrollo de los estudios genómicos en el marco del programa de liderazgo académico 'Priority 2030', elaborado por el Ministerio de Ciencia y Educación Superior del país. Los estudios genómicos han adquirido gran importancia en la nación euroasiática. Recientemente, el presidente Vladímir Putin indicó que en este campo hay muchas cuestiones controvertidas, tanto éticas como legales, y se requiere resolverlas. "También deberían establecerse claramente los límites del uso permisible de las tecnologías genéticas", agregó el mandatario.
La Universidad Nacional de Investigación de Tecnologías de Información, Mecánica y Óptica de San Petersburgo (ITMO) es una de las instituciones educativas que participa en el programa 'Priority 2030' y obtuvo una subvención por importe de 994 millones de rublos (unos 13 millones de dólares). "Planeamos proporcionar una superioridad tecnológica en los mercados de la sensórica, telecomunicaciones, robótica, tecnologías de ahorro de energía; introducir potentes tecnologías de inteligencia artificial para transformar la ciencia clave, procesos empresariales e integrar proyectos digitales para desarrollar métodos de control y regulación de la salud personalizados", destacó Daria Kozlova, jefa del programa de desarrollo de la universidad.

Entre otras esferas, la ITMO se dedica a la investigación las tecnologías genéticas. Científicos de la universidad desarrollaron el algoritmo PaReBrick, que ayuda a aislar y analizar rápidamente adaptaciones paralelas en poblaciones bacterianas. Para ilustrar la eficacia de PaReBrick, los investigadores analizaron conjuntos de datos de unas 200 cepas de 'Streptococcus' y 150 cepas de 'Escherichia coli' patógena, y el algoritmo procesó estos datos en solo un minuto.
El método puede utilizarse para analizar y comparar los genomas de cualquier bacteria, lo que podría "simplificar enormemente el trabajo de médicos, bioinformáticos y biólogos", aseguraron desde la universidad. "El análisis sistemático de un gran número de cepas en términos de evolución de la secuencia y la superposición de esta información en un árbol filogenético apenas se ha hecho antes", indicó Alexéi Zabelkin, coautor del estudio y estudiante de doctorado en Tecnología de la Información y Programación de ITMO.
La institución lleva tiempo contribuyendo al desarrollo de las investigaciones genómicas. Un equipo conjunto de científicos de la ITMO, la Universidad Estatal de San Petersburgo y el Instituto de Biología Molecular y Celular del Departamento Siberiano de la Academia de Ciencias de Rusia fue el primero del mundo en descifrar el genoma del yaguarundí, una especie de puma que habita principalmente en América Central y del Sur, y publicó un artículo con los resultados de su estudio en Journal of Heredity.

Pavel Dobrynin, del Centro de Investigación y Educación sobre la Diversidad Genómica de la ITMO, explicó que, al descodificar un genoma, se puede "averiguar qué características tiene un animal, por qué se comporta de una manera determinada, por qué tiene ese aspecto y cuál es la base genética molecular de todo ello". "Nuestro artículo contribuirá a sentar las bases de nuevas investigaciones sobre el yaguarundí, datos que podrán ser utilizados por otros científicos que estudien la especie", agregó Dobrynin.
"Desarrollar formas de selección competitivas a nivel nacional"
Otra institución educativa rusa que forma parte del programa 'Priority 2030' es la Universidad Estatal Agraria de Rusia–Academia Agrícola de Moscú KA Timiryazeva (RGAU–MSHA, por sus siglas en ruso), que obtuvo una subvención especial en el ámbito 'Liderazgo de investigación'.
Así, en la universidad se abrió un laboratorio dotado de modernos equipos de biotecnología y genética molecular para la investigación y el cultivo de plantas a nivel molecular y celular. El proyecto cuenta con el apoyo de Bayer y busca aumentar la competitividad de la ciencia rusa en el mercado mundial.
"El nuevo laboratorio permitirá a la universidad llevar las investigaciones a un nuevo nivel en el marco de proyectos internacionales, en los que nuestra universidad participa activamente", expresó el rector de la RGAU–MSHA, Vladímir Trujachev.
"Estamos convencidos de que la infraestructura creada para generar nuevos conocimientos y actividades de investigación será la base para el desarrollo de productos innovadores que respondan a los retos actuales de la agricultura en Rusia y en el mundo", destacaron por su parte desde Bayer.
La universidad lleva a cabo el programa 'Agroproryv-2030' ('Agroprogreso-2030') que incluye cuatro proyectos estratégicos: 'Agrociencia: Desafíos globales', 'Formación avanzada para el sector agroindustrial ruso', 'Jóvenes agrolíderes de Rusia' y 'Campus verde'. "Con la puesta en marcha del programa 'Agroprogreso-2030', esperamos conseguir resultados significativos para el sector agrícola, para nuestro país y para el mundo entero", subrayó Trujachev.
Asimismo, la academia organizó un concurso interno entre equipos de investigación con veinte ganadores, cada uno de los cuales recibirá 500.000 rublos (6.755 dólares) para el desarrollo de su proyecto. Uno de los proyectos vencedores es una investigación dedicada a marcadores genéticos de productividad y reproducción en ganado pequeño.
- El programa 'Priority 2030' se inició en junio de ese año y está destinado a crear un gran grupo de universidades líderes en innovación y nuevos conocimientos científicos para 2030.
